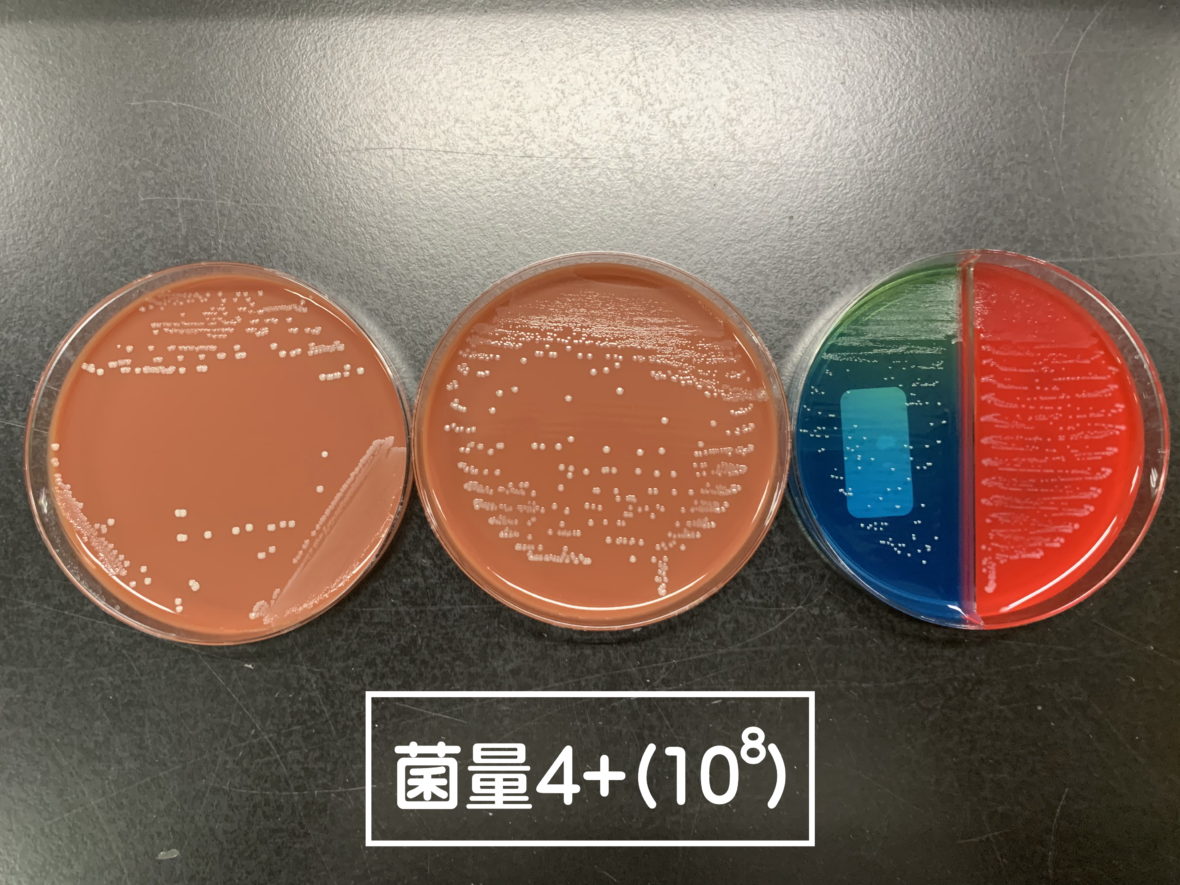
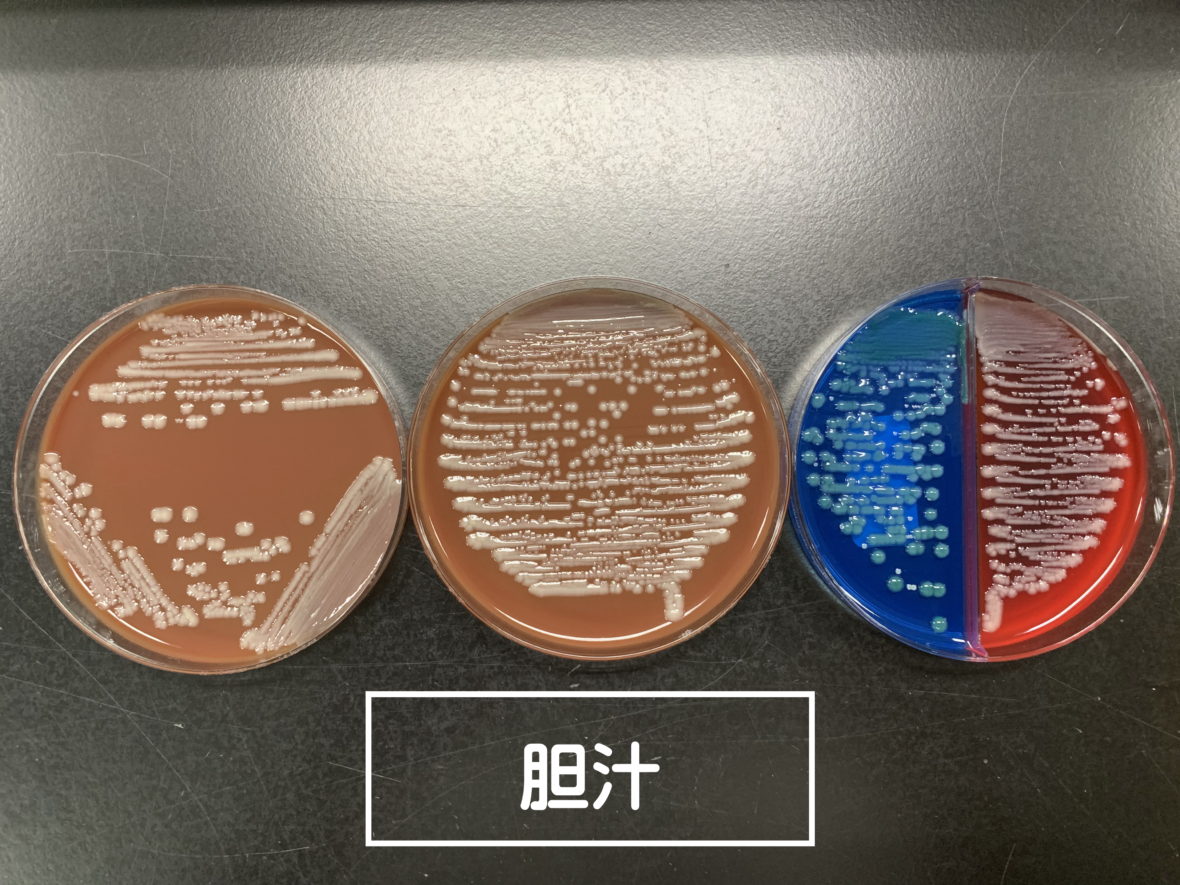

“柵がいらない”人協働ロボット
従来のロボットは安全柵の設置が義務付けられていましたが、労働安全衛生規則の改正により、基準を満たす人協働ロボットは柵なしでの運用が可能になりました。
本装置はカバーや柵を設けることなく、人と同空間で安全に協働作業が行えます。
セミオート(半自動)塗布について
検体の点着、培地の設置、ループの入れ替えはオペレーターが行い画線に特化したシステムです。
カバーや安全柵無しで人と同じ空間で協働作業が可能です。
ロボット動作で画線塗布の均一化を図り、分離性能に優れ釣菌がしやすくなります。
平板培地塗抹動作
平板培地画線
分画培地塗抹動作
分画培地画線
3回培養塗抹動作
3回培養画線
画線パターン/動作速度
平板培地/15秒
分画培地/18秒
3回塗抹/19秒

システム仕様
ロボット:DENSO製COBOTTA
アーム:6軸
操作:タブレット端末
ループ:ディスポーザブルタイプ
外形寸法:横幅404mm×奥行616mm
電源:AC100V,110W
重量:30Kg
設計製造 株式会社興電舎
販売 有限会社メディサイエンス
お見積り・お問い合わせ
以下のフォームよりお気軽にご連絡ください。
